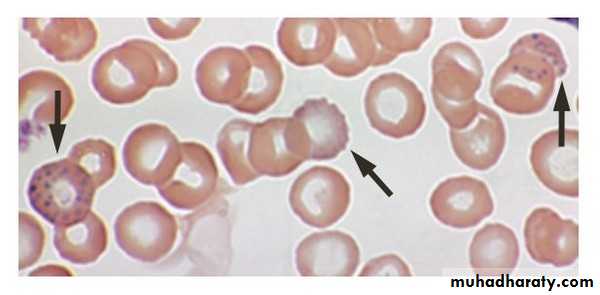

ManagementofPoisoned Patient
Presentation of Poisoned Patient:1-Acute Poisoning in A/E Department.
2-Chronic Poisoning in a Medical Clinic:(In Patient or Outpatient)
3-Presentation at the field of poisoning ex. factory, warfare, battlefield…etc.
Management lines:1-Clinical Stabilization.
2-Clinical History.3-Physical Examination.
4-Investigations:
-Laboratory
-Radiology
-ECG
5-Prevention of further absorption:
-Topical.
-Inhalation.
-Gastrointestinal.
6-Enhancement of Poison Elimination:
- Alkalinization of Urine.-Dialysis.
7-Use of Specific Antidote.
8-Supportive Care.
1-Clinical Stabilization:
Airway, Breathing, Circulation-Vital Signs.
-Respiration.- Administration of Oxygen.
-Circulation, Intravenous Hydration If needed.
-Control of seizure with diazepam.
-Ventilation.
These are quite vital even in lethal dose of poisoning.
(Proper Positioning of the Patient)
(Ensure Patent Airway)
(Insert Airway Tube if needed)
2-Clinical history:-Determine “If Possible” the Substance Ingested.
-Occasionally the history is Unreliable or Unobtainable.
-In intentional poisoning there might be incorrect information.
Family member or medical personal might be helpful.Circumstantial evidence:
Empty Drug Container.Empty sheet
Maximize the possible dose!
3-Physical examination:
-General condition of the patient.-Pulse rate, Rhythm (Regular, Irregular).
-Blood Pressure.
-Pupils.
-Mental state.
-Other trauma or accidental injury.
-Check the Gag Reflex (Pharyngeal Reflex)
Toxic syndromes (toxidromes):
-Narcotic Toxic Syndrome.
-Cholinergic Toxic Syndrome.
-Sympathomimetic Toxic Syndrome.
Narcotic toxic syndrome:
Categorize the patientComa + Miosis (Pin Point Pupil) + Hypotension + Bradycardia + Low respiratory rate +Hypothermia
• Pinpoint Pupils (Narcotics)
• Normal Pupils(Pinpoint Pupils)
Toxic syndromes (Toxidromes)
Other signs of chronic poisoning:-CNS Signs (Diminished Reflexes, Abnormal Gait)
-Marks of Needles.-Tattoo Marks
-Other signs ex. Gingival lines in chronic lead poisoning.(Blue line of chronic lead poisoning)
(Blue line of chronic lead poisoning)
(Signs of Needles in Chronic Opiate Addiction)
(Signs of Needles in Chronic Opiate Addiction)
(Signs of Needles in Chronic Opiate Addiction)
(Pigmentation in Chronic Arsenic Poisoning)
(Some Poisons have Special odor)
4-Investiations:A-Laboratory Evaluation:
There is a common misconception about laboratory diagnosis of poisoning.Rapid assays are very limited !
List of Drugs
CommonlyMeasured in
Hospital Settings
Quantification is important from Prognostic and Therapeutic point of view.
Plasma concentration of the poison is measured.
Affect decision to treat might depend on plasms concentration.
Carboxy hemoglobin is measured in CO poisoning
Decision to treat according to concentration:
-Lithium-Digoxin
-Iron
-Phenobarbital
-Theophylline
-Aspirin
-Paracetamol
Action Plasma level:
Ex.A patient with a non toxic Digoxin concentration could have symptoms of toxicity.
Or a patient with elevated Digoxin level could have no symptoms of toxicity.
The rule is to :
Treat the patient and not the laboratory data!Anion Gap & Osmolal Gap:
1-Anion Gap:Help in the Differential diagnosis of poisoning.
Difference between Sodium vs. Chloride + BicarbonateAnion gap = Na Conce. mEq/L – (Cl+HCO3)
Normal Level is < 122-Osmolal Gap:
Difference between:Measured plasma osmolality Vs.
Calculated plasma osmolalityCal =2 X Na+ (Glucose/18)mg/dl + BUN/2.8 mg/dl
Normal:<10 mOsm at freezing point measurement.
B- ECG
ArrhythmiaEx. Tricyclic Antidepressants (TCA)
Digoxin.Theophylline.
C-Radiographic examination:
-Limited role.-Lack of Radiopacity. (Undetectable by x ray).
Ferrous or Potassium salt could produce significant opacities.
Enteric coated formulations or restrained release could be opaque, Lead pica (in children)-CXR.
-Plain X ray Of the Abdomen.
-CT Scan.
Carbon tetrachloride and chloroform are radio opaque in gut lumen.
Foreign Body in GIT (Body packers)Latex plastic storage.
Non cardiac pulmonary oedema.
Carbon monoxide poisoning could show lesions in brain in CT scan.
Basophilic Stippling
(Lead Poisoning)5-Prevention of further absorption:
-Topical.-Inhalation.
-Gastrointestinal
The Aim is to:
Minimize the total amount of poison reaching the circulation.In Inhalation of Toxicant Ex. Carbone monoxide poisoning:
-Remove the patient from the site of exposure.
-Adequate ventilation
-Oxygen
In topical exposure:
-Remove the contaminated clothes.-Airtight raping.
-Evacuation of the patient.
-Pay attention to Secondary exposure to rescuers.
-Gentile washing with water and mild soap.-Not to encourage absorption of the poison.
-Act As soon as possible.Gastro intestinal:
-Induction of emesis using syrup of ipecac.-Gastric lavage.
-Activated charcoal.
-Home use of ipecac upon advice of poison information center.
-15-20 ml of syrup of Ipecac with water.
-Vomiting within 30 minutes.Syrup of Ipecac
Contraindication of ipecac:1-Children under 6 months.
2-Caustic agents.3-Low consciousness.
4- Risk of aspiration of gastric content ex. Kerosene poisoning.
Gastric lavage:
Nasogastric or Orogastric tube aspiration of gastric fluid and aspiration until the effluent is clear.-Use Large Orogastric tube of 40 – 44 fr
-Rule of Gastric lavage has diminished recently.
-Growing appreciation of the risk of aspiration.
-Check the Gag reflex.(Oropharyngeal Reflex).
-If negative put endotracheal tube to protect the airway.
Time of Overdose < one hour
Activated Charcoal:
Charcoal is very old method (around 150 years old)Lethal dose of Strychnine was ingested by Professor Touery in French Academy of Medicine 1831.
(He Survived to tell the story!)
-Activation leads to increased adsorption
-Prepared From burning of carbon wood pulp, sugar organic matter, or industrial waste.Treated with Co2 , O2, Zinc, Chloride at high temperature (500- 900 F)
(Activated Charcoal)
Activated Charcoal
(Activated Charcoal)
6-Enhance poison elimination:-Alkalinization of urine
-Haemodialysis.- Hemoperfusion.
-Peritoneal Dialysis.
-Haemofiltration.
-Plasma Exchange Transfusion.
Urine alkalanization:
Enhance Excretion of Weak acids.
Increase PH of urinary filtrate leads to ionization of weak acids. (Salicylate + phenobarbitone)-Sodium bicarbonate + 5% dextrose
-PH of Urine is 7.5 – 8.5*Ensure adequate urine flow (Avoid dehydration).
Dialysis:-Peritoneal dialysis.
-Haemodialysis.
Semi Permeable membrane (Dialysis Membrane)
Useful In Drugs With:
-Low volume of distribution.-Low protein binding.
-High water solubility.
-Low molecular weight.
Ex. In Digoxin not useful
Haemodialysis
(Haemodialysis)
(Haemodialysis)
Haemodialysis is effective to clear some drugs some drugs
Hemoperfusion:-Perfusion cartridge adsorption
(Activated charcoal)
Complications of Hemoperfusion:
-Thrombocytopenia-Hypocalcaemia
-leucopenia
(Hemoperfusion)
(Hemoperfusion Unit)
(Hemoperfusion Cartridge)
(Hemoperfusion Cartridge)
7-Use of Antidote:Small number of Antidotes are available.
(Because of lack of drug development & Small market)
Ex.
-Chelating agents.
-Fab Antibody for Digoxin.
-Naloxone.
- Desferrioxamine.
- N-acetylcysteine.
Fab Antibody for
Digoxin8-Supportive care of poisoned patient:
-In patient care for unstable (At Risk) patients.-ICU for Critical Patients.
-Heavy sedation when needed.
-Pay attention to Iatrogenic fluid and electrolyte disturbances.
-Endotracheal intubation when needed (Loss of gag reflex).